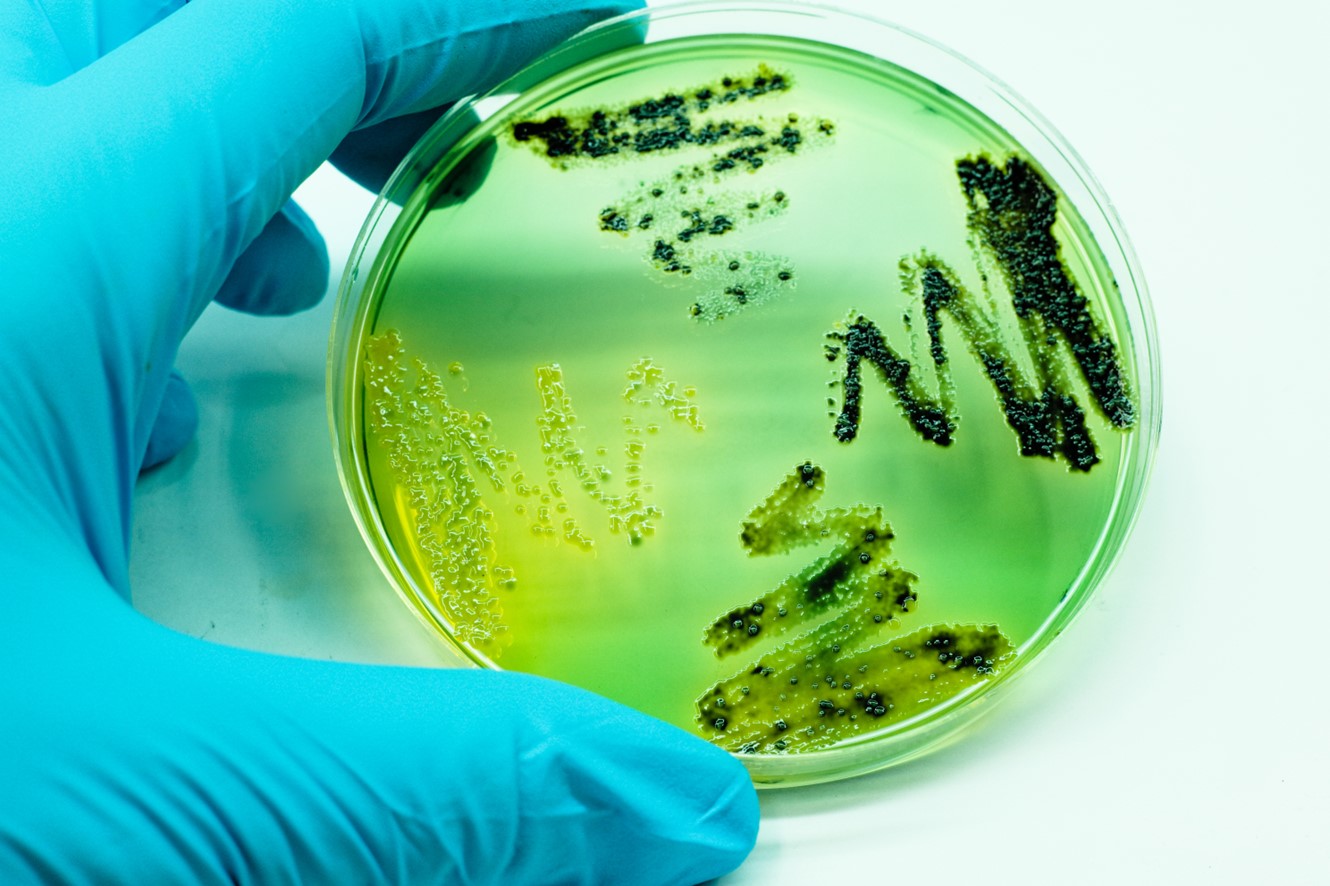

Maintaining Low Endotoxin Levels in Microorganisms: Best Practices
Microorganisms are widely utilised in biotechnology due to their rapid growth and ease of modifying them according to specific requirements. They can be used as a whole, such as in the production of biomass for livestock feed. They can also be harnessed for specific abilities, such as bioremediation or biofertilizers. Additionally, their metabolites can be extracted and purified for various applications in research, clinical diagnosis, dietary supplements, and even pharmaceuticals.
Unveiling Endotoxin Challenges
Bacteria and yeast are the most used microorganisms in biotechnology. Notably, E. coli and lactic acid bacteria like Lactobacillus are prevalent among bacteria, while Komagataella phaffii and Kluyveromyces lactis are commonly used yeasts.
Gram-negative bacteria possess lipopolysaccharides, known as endotoxins, in their cell membranes. While these compounds do not harm microorganisms themselves, they can cause severe damage to complex organisms like humans. Inactivation of endotoxins requires higher temperatures than those achieved through autoclaving, making it challenging to ensure their absence in laboratory materials and cultures.
Therefore, industries that utilise microorganisms seek culture media with low endotoxin levels, particularly in the production of drugs and dietary supplements. This minimizes the saturation of purification systems, even when working with bacteria like E. coli that naturally produce endotoxins.
Crafting Endotoxin-Free Culture Media
Peptones, commonly used in culture media formulation, often contain high endotoxin levels. Traditional elimination methods, such as ultrafiltration, pose challenges by also removing larger peptide fragments. Introducing Condalow®, a peptone product line from Condalab, offers a solution – low in endotoxins and free from ultrafiltration.
To address this issue, Condalab has developed Condalow®, a line of peptone products with low endotoxin levels that do not require ultrafiltration. Condalow® is the ideal ingredient to enhance the growth of microorganisms and facilitate the synthesis of desired proteins. Most importantly, it ensures an endotoxin level below 200 units per gram.

Lab Unlimited is a trusted supplier of Condalab products, including the innovative Condalow® line. Explore our comprehensive range of Condalab products and find the perfect solutions for your needs. Don't miss out on the opportunity to enhance your microorganism-based applications with Condalow®.
|
To find out more: |
